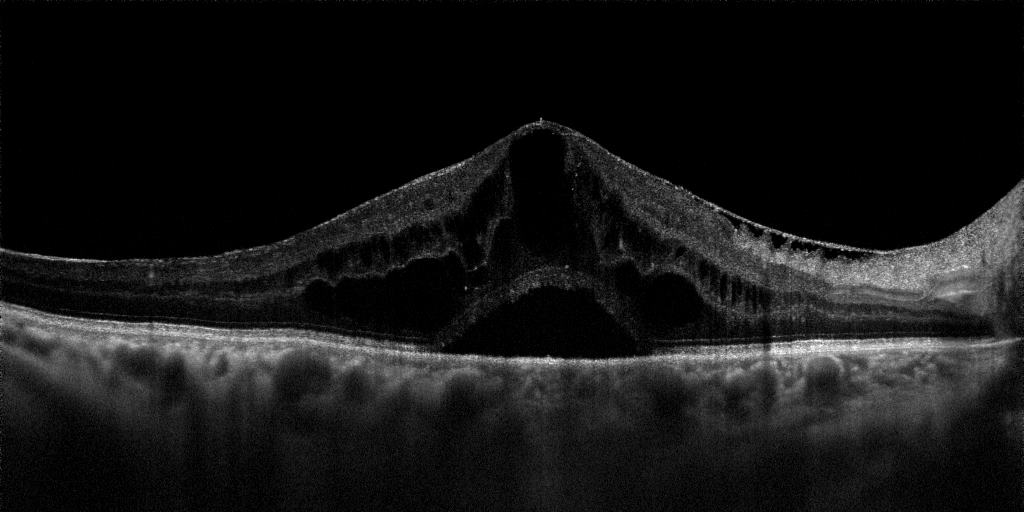

L’OCT Heidelberg Spectralis Blue Peak, installato presso il nostro centro, è uno strumento unico per l’imaging della retina. E’ un tomografo a dominio spettrale che combina un OCT spectral domain con una tecnologia a scansione laser confocale. Questa tecnologia abbinata all’eye tracking attivo e alla autofluorescenza laser blu ci fornisce oggi uno strumento formidabile per la diagnostica avanzata della retina. Produce 40.000 scansioni al secondo con il dettaglio più piccolo misurabile di 1-3 Micron (esame istologico in vivo), grazie alla funzione Auto rescan lo SPECTRALIS nei controlli successivi dello stesso paziente può posizionarsi negli stessi punti arrivando a rilevare variazione dell’anatomia retinica con un dettaglio di 1 micron. Questo può far capire la sua utilità nel rilevare qualsiasi peggioramento della malattia oculare in corso di maculopatie, retinopatie, glaucoma ecc.
Autofluorescenza: Senza l’iniezione di fluoresceina endovenosa la fluorescenza laser blu sfrutta la spontanea fluorescenza della lipofuscina, un prodotto del metabolismo retinico, consentendo di ottenere immagini fluorescenti e seguire l’andamento della senescenza retinica, delle maculopatie e della retinopatia diabetica in base a precisi pattern.